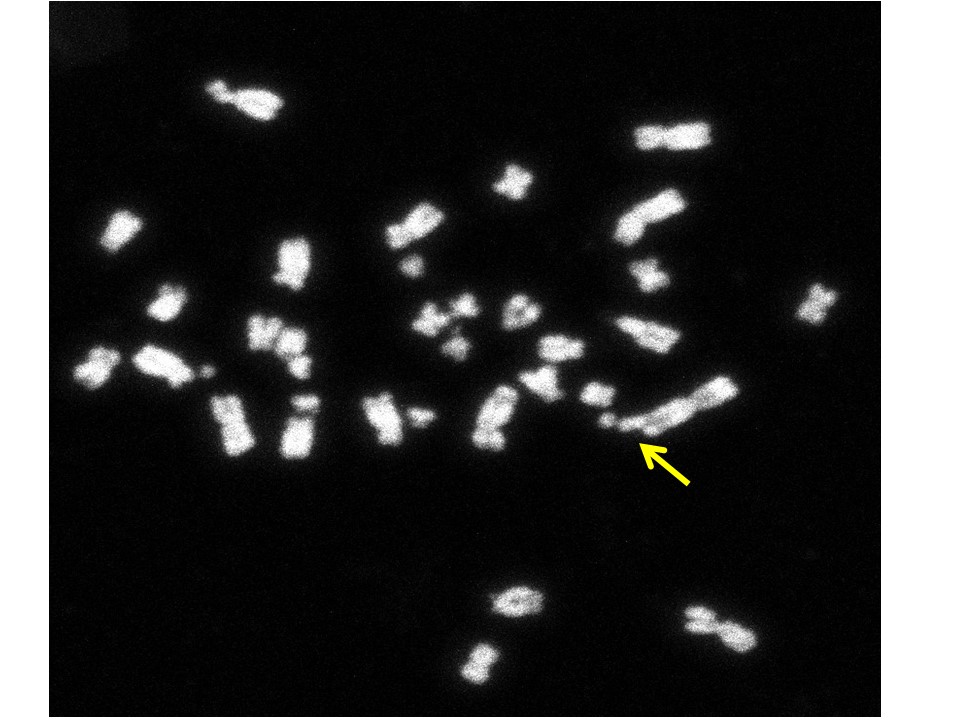
Selected image

Παρουσίαση/Προβολή
ΒΙΟΛΟΓΙΑ ΙΙ
(MED801) - Ζωή Λυγερού, Βασίλης Ρούκος, Γιάννης Δρόσος, Ελένη Σάκκουλα, Παναγιώτης Καραχάλιος
Περιγραφή Μαθήματος
Σας καλωσορίζουμε στην ηλεκτρονική τάξη (eclass) του μαθήματος Βιολογία ΙΙ του Α' έτους σπουδών του Τμήματος Ιατρικής, Πανεπιστημίου Πατρών.
Στα "Έγγραφα" θα βρείτε το πρόγραμμα μαθημάτων και την ύλη του μαθήματος, τις παρουσιάσεις των παραδόσεων και φροντιστηρίων καθώς και υλικό για τα Εργαστήρια και τη Διδασκαλία Μικρών ομάδων.
Στις "Εργασίες" θα μπορείτε να ανεβάσετε τις εργασίες που σας έχουν ανατεθεί στα εργαστήρια και τη Διδασκαλία Μικρών Ομάδων του μαθήματος.
Στους "Συνδέσμους" θα βρείτε χρήσιμες και ενδιαφέρουσες επιπρόσθετες πληροφορίες για θέματα που συζητάμε στο μάθημα.
Οι "Ανακοινώσεις" θα αποστέλλονται στο ιδρυματικό ηλεκτρονικό σας ταχυδρομείο (upnet ή upatras) το οποίο θα πρέπει να ελέγχετε τακτικά.
Η εικόνα αριστερά δείχνει μεταφασικά χρωμοσώματα του ανθρώπου. Με το κίτρινο βέλος φαίνεται ένα χρωμόσωμα που φέρει έλλειψη. Aπό την Ομάδα Κυτταρικού Κύκλου http://ccl.med.upatras.gr/
Ημερομηνία δημιουργίας
Τρίτη 2 Δεκεμβρίου 2
-
Στόχοι
Κύριοι στόχοι του μαθήματος είναι :
> η κατανόηση των κομβικών εννοιών της Ιατρικής Γενετικής και των τεχνολογιών, δυνατοτήτων και δεδομένων της Μοριακής Γενετικής Ανάλυσης
>η ανάπτυξη της δυνατότητας αντίληψης της μοριακής βάσης των γενετικών ασθενειών, της συμβολής του γενετικού υλικού των ατόμων στην εκδήλωση όλων των νοσημάτων και των εφαρμογών της γενετικής και γονιδιωματικής στην Ιατρική Ακριβείας
Περιεχόμενο Μαθήματος
Η διδακτέα ύλη αφορά σε βασικές αρχές της Ιατρικής Γενετικής όπως: δομή και λειτουργία του ανθρώπινου γονιδιώματος, γενετική ποικιλότητα και τύποι γενετικών παραλλαγών, ανθρώπινη εξέλιξη, εξέλιξη γονιδιωμάτων, μοριακή βάση της παθογένειας, γονότυπος, φαινότυπος και περιβάλλον, επίδραση του γενετικού υλικού στα νοσήματα και εφαρμογές στην Ιατρική Ακριβείας, πρότυπα νοσήματα μονογονιδιακής και παλυπαραγοντικής κληρονομικότητας, χρωμοσώματα και χρωμοσωματικές ανωμαλίες, γενετική του καρκίνου, τεχνολογία του DNA, μοριακή διάγνωση, γονιδιακή θεραπεία
Μέθοδοι διδασκαλίας
Α. Διαλέξεις ·
Παρακολούθηση : ακαδημαϊκή, Περιεχόμενο : Παρουσίαση ύλης απο διδάσκοντες, Ύλη στα έγγραφα
Β. Φροντιστήρια
Πέμπτη 9.00 11.00, Παρασκευή 15:00-18:00, Παρακολούθηση : υποχρεωτική, σε ομάδες, Θεωρητική εμβάθυνση σε προ-επιλεγμένο θέμα που έχει ηδη διδαχθεί στις διαλέξεις. Κύριος ο ρόλος του διδάσκοντος αλλά απαιτείται η ενεργός συμμετοχή των διδασκομένων
Γ. Εργαστηριακές Ασκήσεις
Παρακολούθηση : υποχρεωτική, Οργάνωση: Ασκηση κατά Ομάδες (8 ομάδες, Α1, Α2, Β1, Β2 κοκ), Περιεχόμενο : Πρακτική-Εργαστηριακή Ασκηση με υπεύθυνους διδάσκοντες, Aξιολόγηση: σύντομα τεστ στο τέλος της άσκησης, παράδοση εργασιών με επεξεργασία των δεδομένων της άσκησης
Δ. Διδασκαλία σε Μικρές Ομάδες
Παρακολούθηση : υποχρεωτική. Οργάνωση : σε 8 ομάδες ( Α1, Α2, Β1, Β2, κλπ). Περιεχόμενο : Συζήτηση προ-επιλεγμένου θέματος. Κύριος ο ρόλος των φοιτητών /τριών μελών Μικρής Ομάδας οι οποιοι, με την επίβλεψη του διδάσκοντος οδηγούν τη διαδικασία.
Αξιολόγηση: Παράδοση βιβλιογραφικής εργασίας (minireview) από κάθε φοιτητή σε προεπιλεγμένα θέματα.
Βοηθήματα
Βασικά Βιβλία (παρέχονται δωρεάν): ·Iατρική Γενετική, Thomson & Thomson, Εκδοση 7η, Ελληνική Μετάφραση, Ιατρικές Εκδόσεις Π.Χ. Πασχαλίδης, Βασικές Αρχές Κυτταρικής Βιολογίας, Εισαγωγή στη Μοριακή Βιολογία του Κυττάρου, Alberts, Bray, Johnson, Lewis, Raff, Roberts, Walter, Ελληνική Μετάφραση, Ιατρικές Εκδόσεις Π.Χ. Πασχαλίδης · .
Βιβλιογραφία που υπάρχει στην βιβλιοθήκη της Ιατρικής 1. GENES VII, Benjamin Lewin 2. Principles of Medical Genetics, T.D.Gelehrter & F.S.Collins, Iατρική Γενετική, Thomson & Thomson, Εκδοση 2η, ΠΕΚ.
Επίσης παρέχονται : · Εργαστηριακές σημειώσεις · Οδηγοί Σπουδών για επιλεγμένα θέματα,
Ανθρώπινο Δυναμικό
Ζ.Λυγερού, Καθηγήτρια, Διευθύντρια του Εργαστηρίου Γενικής Βιολογίας
Ι.Ζαρκάδης, Καθηγητής
Β. Ρούκος, Επικ. Καθηγητής
Δρ. Ε. Σάκκουλα, ΕΔΙΠ
Δρ. Τ. Καραχάλιος, ΕΤΕΠ
Συμμετέχουν στη διδασκαλία
Γ.Ν. Μοσχονάς, Ομότιμος Καθηγητής
Μ. Αρμπή, Παν. Υπότροφος
Ε. Στεφάνου, Συνεργάτης
Υποψήφιοι διδάκτορες Εργαστηρίου Γεν. Βιολογίας (Επικουρικό Έργο)
Τρόποι αξιολόγησης / εξέτασης
>>Γραπτές εξετάσεις στο τέλους του εξαμήνου. 70% του τελικού βαθμού. Απαραίτητος βαθμός >=5.
>> Εργασίες Εργαστηρίων, Βιβλιογραφική Εργασία στη Διδασκαλία Μικρών Ομάδων και σύντομα μικρά τέστ στο τέλος των ασκήσεων. 30% του τελικού βαθμού. Απαραίτητος βαθμός >=5.
